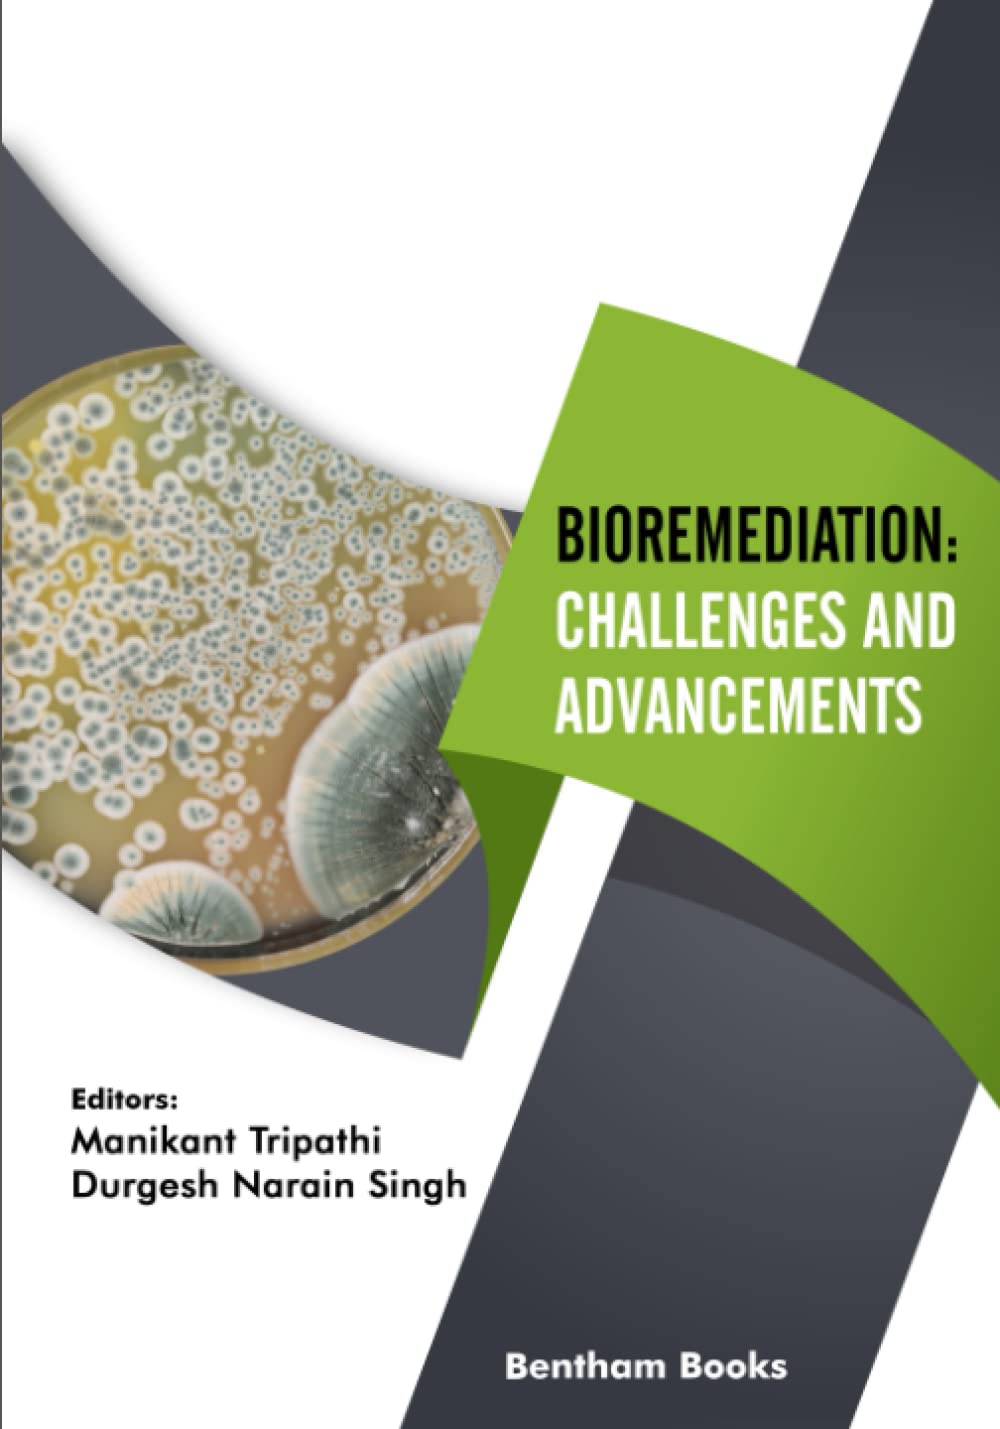

By Manikant Tripathi, Durgesh Narain Singh Waste management is one of the major challenges for environmental and public health organizations for maintaining safety standards in any area. Population growth and urbanization increase the difficulty in maintaining a sustainable waste management system. Bioremediation refers to the use of living organisms in processes designed to remove toxic chemicals present in waste material. Bioremediation represents a sustainable way to remove a range of environmental pollutants.Bioremediation: Challenges and Advancements covers the subject of bioremediation in eight chapters that focus on a broad range of waste sources, their adverse impacts on the ecosystem, and the advanced strategies for their remediation. Each chapter also highlights the problems encountered in bioremediation processes. Key features:- Comprehensive coverage of bioremediation in 8 reader-friendly chapters- Highlights methods and challenges of bioremediation in one volume.- Introduces the reader to bioremediation- Explains recent biotechnological methods for removing heavy metals and xenobiotic compounds- Describes strategies including physical, chemical, and biological methods to mitigate radioactive waste from contaminated sites and water bodies- Details the use of microbial-aided remediation techniques for the management of biomedical and electronic wastes, and its impact on the ecosystem- Describes bioremediation technologies for decontamination of solid waste pollutants- Showcases the application of Omics approaches such as genomics, transcriptomics, proteomics, and metabolomics to improve bioremediation processes.- Covers bioremediation of agro-wastes- Includes detailed references This book is an informative reference for scholars (researchers, undergraduate and graduate students of environmental sciences, microbiology and biotechnology) professionals (environmental engineers) and researchers, giving each a good understanding of the significance of bioremediation in solid waste management and the restoration of contaminated sites.
Product Details
Publisher : Bentham Science Publishers (March 8, 2022)
Language : English
Paperback : 276 pages
ISBN-10 : 981503605X
ISBN-13 : 978-9815036053

Reviews
There are no reviews yet.